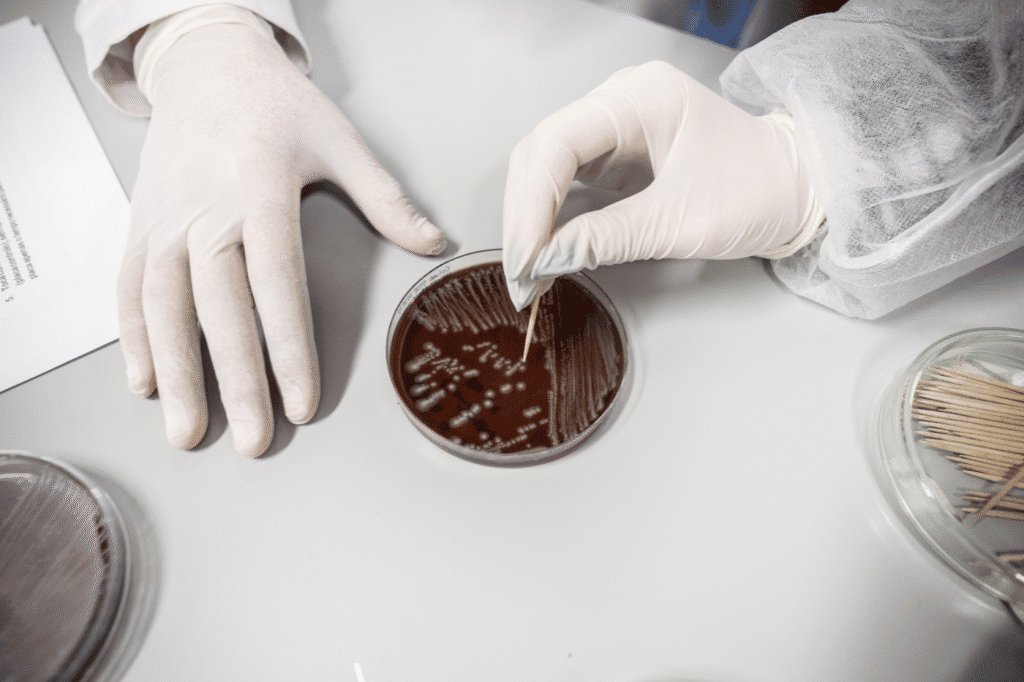

Reitores querem mais recursos para a nova agência de investigação
A proposta de criação da Agência de Investigação e Inovação arrisca-se a ser uma “oportunidade perdida” e uma “reorganização administrativa” que falha em mudar a cultura e os incentivos do sistema científico nacional, segundo o parecer do Conselho de Reitores das Universidades Portuguesas.